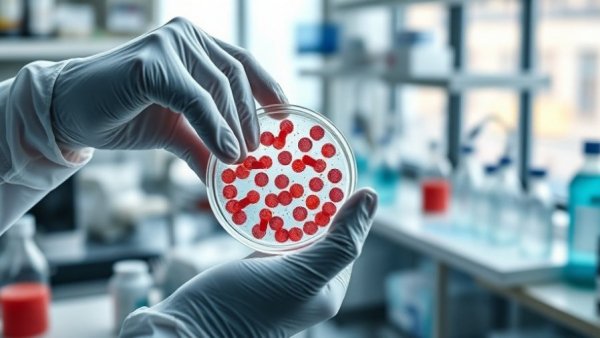
Scientist handling petri dish examining cells related to COVID long-term effects.

Trump’s Shifting Narrative on COVID-19 Long-Term Effects Questions Federal Policy Direction
As the world navigates the aftermath of the COVID-19 pandemic, new research is surfacing regarding the virus’s long-term health implications. Despite the official declaration in May 2023 that the national pandemic phase had ended, studies indicate that the effects of the virus could linger much longer, challenging previous understandings and government policies. The evolving narrative raises critical questions about the Trump administration's strategies and their alignment with emerging scientific insights.
Emerging Research: Long COVID’s Growing Evidence
Recent research highlights grim possibilities associated with COVID-19 that surface long after the initial infection, even when symptoms have been mild. Concerns now include increased risks of neurodevelopmental issues in children born to mothers infected with the virus, and warnings about dormant cancer cells being awakened by COVID-19. The implications of long COVID are profound, leading experts to call for more extensive funding for research and long-term monitoring of affected populations.
The Federal Response: Constraints and Challenges
As scientists raise alarms over the chronic impacts of COVID-19, the response from the federal government has been mixed. The Trump administration has notably reduced recommendations around vaccinations, maintaining that vaccines are still available while limiting who should receive them. This stance contrasts sharply with the ongoing call from researchers for comprehensive, large-scale studies to assess long-term health consequences, suggesting a disconnect between scientific data and policy.
Economic Burdens: Understanding the Implications
The economic consequences of long COVID are daunting, with estimates suggesting that the long-term health effects may place a $1 trillion burden globally, translating to approximately $9,000 per patient in the U.S. Additionally, the loss of earnings due to health issues related to COVID is estimated to be around $170 billion annually. These staggering figures hint at the profound societal and economic challenges that could result from neglecting the health implications of the virus.
Political Underpinnings and Public Health Decisions
Critics argue that the politicization of health policy has obfuscated clear scientific guidance about COVID-19. With the halting of contracts aimed at developing more protective vaccines observed during the Trump administration, experts emphasize that every funding cut compromises public health. The focus on political narratives rather than scientific truths raises urgent questions about future governmental health strategies, especially as communities continue to grapple with the aftermath of the pandemic.
Conclusion: Building a Responsive Health Policy
The emerging understanding of COVID-19's lingering effects calls for a re-evaluation of America’s public health policy framework and funding priorities. As the nation forges ahead, it is vital for leaders to balance political agendas with scientific integrity to ensure that the challenges posed by long COVID do not become an afterthought in the broader public health response. Addressing these health implications head-on, rather than sidelining them in political rhetoric, is fundamental to safeguarding the well-being of all Americans.





Write A Comment